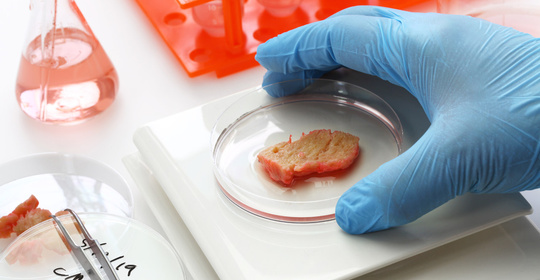

皮膚健康
頭:毛囊炎的自愈與治療



頭:毛囊炎,處理方式



頭:毛囊炎的飲食與治療



食物過敏:腹瀉、蕁麻疹、拉肚子、皮膚瘙癢的處理方法



食物過敏:腹瀉、拉肚子、脹氣、皮膚過敏的處理與預防



鱗屑:乾癬性關節炎的症狀與飲食管理



鱗屑:乾癬就診科室選擇與管理




痱疹樣皮疹:症狀與治療
本文介紹了皰疹病毒感染的症狀,包括水泡、疼痛、發燒、頭痛和疲勞,並強調了及時就醫的重要性。該疾病可能導致嚴重的健康問題,因此患者應密切關注病情變化並接受專業醫療指導。
痱疹樣皮疹:預防與治療



瘡毒:疔瘡與痤瘡的處理方法



瘡毒:抗生素治療與皮膚護理



癬:症狀、原因和治療方法



癬:癬斷清藥膏外用治療皮膚真菌感染



�癬:股癬與體癬的差異與診斷要點

癬:傳播方式與治療方法



皮膚乾枯:黴菌感染所致?



皮膚乾枯:補充營養素與日常護理



皮膚乾枯:治療方法與恢復時間



皮膚乾枯:注意事項與飲食宜忌



皮膚乾而發紅:處理方式與治療建議


